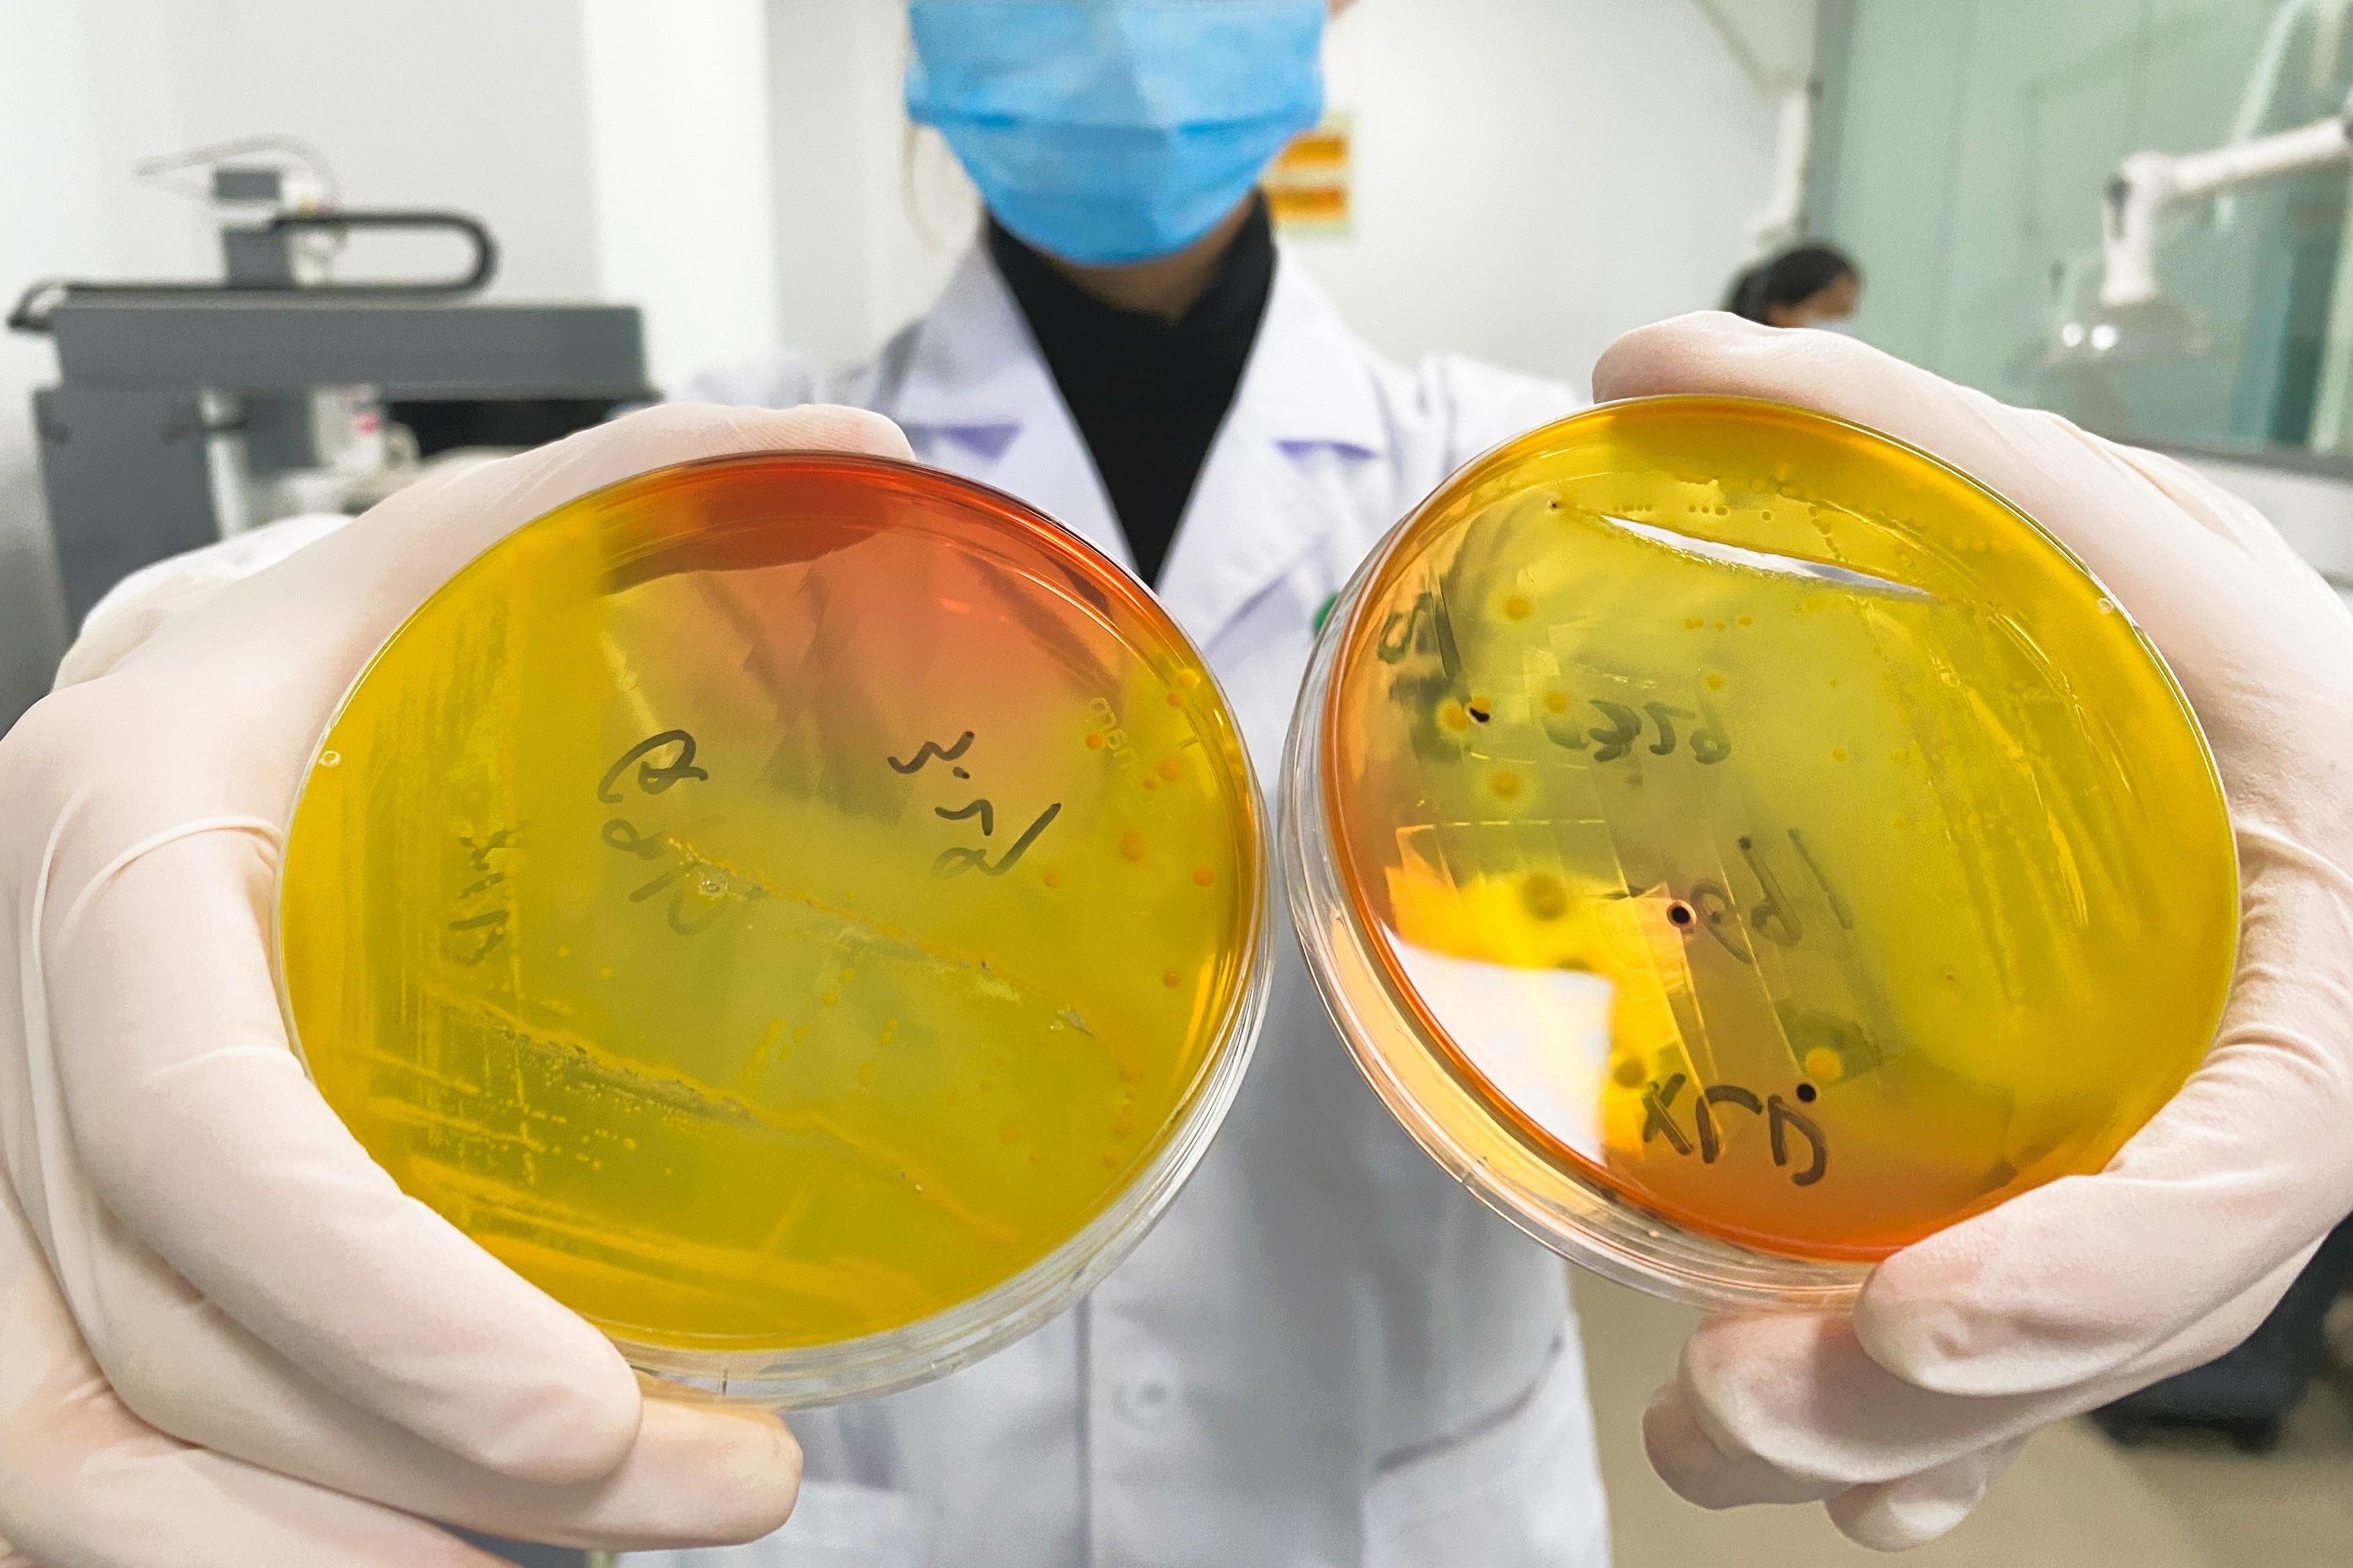
体外功效测试靠谱吗？

用细胞养出来的测试数据,能代表真人皮肤的真实反应吗?体外功效测试结果和人体临床结果之间,到底存在多大的差异?这些问题困扰着许多化妆品企业的研发和备案人员。
体外功效测试是通过细胞模型、3D皮肤模型、生化反应体系等模拟人体生理环境,在实验室条件下评估化妆品功效的检测方法。这类测试涵盖自由基清除能力、胶原蛋白合成促进、细胞活性保护、黑色素抑制等多个维度,具有周期短、成本低、重复性好等优势。然而,体外测试能否完全替代人体临床验证?答案是:不能,但它是功效评价体系中不可或缺的“第一道筛”。
一、体外功效测试的科学基础
1、抗氧化功效测试:采用DPPH自由基清除法和ABTS自由基清除法,通过分光光度计测定化妆品清除自由基的能力。DPPH自由基清除率≥50%为有效(QB/T 4656-2022)。该方法反应快、重现性好,是抗氧化功效体外验证的黄金标准。但需注意,自由基清除能力不等于人体皮肤上的抗氧化效果,后者还涉及透皮吸收、生物转化等复杂过程。
2、抗皱功效测试:采用人成纤维细胞模型,通过酶标仪或流式细胞仪检测产品对胶原蛋白I型和III型表达的促进作用。依据GB/T 35826-2018《化妆品抗皱功效评价指南》,要求胶原蛋白合成率较对照组提升≥20%。该模型能有效筛选具有抗皱潜力的活性成分,但无法模拟皮肤微环境中的细胞间相互作用。
3、美白功效测试:采用小鼠黑色素瘤细胞(B16细胞)或人黑色素细胞模型,通过酪氨酸酶活性抑制试验评估产品对黑色素生成的抑制作用。同时可测定黑色素含量变化,量化美白效果。该模型已被广泛应用于美白成分的体外筛选,但细胞在体外可能表现出与体内不同的黑色素代谢特征。
4、抗光老化测试:采用HaCaT角质形成细胞或成纤维细胞,模拟紫外线照射后细胞的损伤和修复过程。通过MTT法或CCK-8法测定细胞活性,评估产品对UV损伤的保护作用。要求UV损伤后细胞存活率≥80%(ISO 10993-5)。该模型可筛选抗光老化活性物,但无法完全模拟人体皮肤复杂的防晒和修复机制。
5、滋养功效测试:依据《化妆品滋养功效测试方法》团体标准,体外发束滋养功效测试采用梳理力/功、摩擦力/功和光泽度参数进行评估。使用前后参数具有显著性差异,可判断产品是否具有头发滋养功效。该方法操作简便、可重复性强,但无法评估产品对头皮的实际滋养效果。
二、体外功效测试的优势
1、周期短、成本低:体外测试通常2-4周即可完成,费用仅为人体验证的1/5-1/10。在配方筛选阶段,可快速淘汰无效配方,大幅降低研发成本。
2、重复性好、干扰因素少:体外测试在标准化的实验室条件下进行,避免了人体试验中个体差异、环境因素、心理因素等干扰,数据可重复性强,便于不同批次产品间的横向比较。
3、无伦理限制:体外测试使用细胞、组织模型或生化试剂,不涉及人体和动物试验,完全符合化妆品行业“无动物测试”的伦理要求。
4、高通量筛选能力:可同时测试数十个配方或成分,快速筛选出最优候选方案。96孔板、384孔板等高通量平台可实现自动化、规模化检测。
5、机制研究深入:可针对特定靶点(如酪氨酸酶、胶原酶、自由基)进行机制层面的研究,明确活性成分的作用通路和分子机制,为功效宣称提供深度科学依据。
三、体外功效测试的局限性
1、缺乏皮肤屏障考量:体外测试通常直接将样品与细胞或生化试剂接触,忽略了皮肤角质层屏障对活性成分透皮吸收的限制。一个成分在体外表现出优异的抗氧化活性,并不代表它能通过皮肤屏障并到达目标细胞。
2、代谢差异:体外培养的细胞缺乏人体皮肤中复杂的代谢酶系统和循环系统,无法模拟活性成分在体内的代谢转化过程。某些前体物质需要在体内转化为活性形式才能发挥作用,体外测试可能低估其功效。
3、单一靶点的局限:体外测试通常针对单一靶点(如酪氨酸酶抑制、自由基清除),而人体皮肤的功效实现往往是多靶点、多通路的协同作用。一个成分在单一靶点上表现突出,未必能转化为整体的皮肤改善效果。
4、缺乏长期安全性数据:体外测试通常为短期暴露(几小时到几天),无法评估长期使用可能产生的累积效应、耐受性变化或慢性刺激风险。
5、与人体数据的相关性:多项研究表明,体外测试与人体临床测试的相关性通常在0.6-0.8之间。一个成分体外测试效果显著,人体测试可能因透皮吸收差、皮肤代谢快等原因效果不佳;反之亦然。
四、体外测试与人体临床测试的互补关系
1、分阶段验证策略:科学的产品功效验证应采用“体外初筛→3D皮肤模型验证→人体临床测试”的分阶段策略。体外初筛快速筛选有效配方;3D皮肤模型(如EpiSkin、EpiDerm)可模拟皮肤屏障和代谢功能,提供更接近人体的数据;人体临床测试是功效宣称的最终依据。
2、人体滋养功效测试方法:依据《化妆品滋养功效测试方法》团体标准,人体测试采用盲法试验设计,选择30名以上受试者,至少使用受试物2周,通过皮肤平滑度检测仪、光泽度检测仪、角质层水分含量检测仪等仪器测定使用前后参数。主要参数包括皮肤平滑度、光泽度、水分含量等,统计分析后判断是否有显著性差异。
3、功效宣称的法规要求:根据《化妆品功效宣称评价规范》,具有抗皱、紧致、舒缓、修护等功效的产品,应当通过人体功效评价试验方式进行功效宣称评价。体外测试数据可作为辅助证据,但不能单独作为功效宣称的依据。
4、体外测试的适用场景:体外测试在以下场景中具有不可替代的作用:配方筛选与优化、活性成分机制研究、非功效宣称类产品的品质验证、出口产品的预筛查、不具备人体试验条件的产品(如某些工业用途产品)。
五、2025年体外测试技术新进展
1、3D皮肤模型应用:3D重建人体皮肤模型(如EpiSkin、EpiDerm、SkinEthic等)已广泛应用于体外功效测试。这类模型包含基底膜、角质层等多层结构,能模拟皮肤屏障功能,测试结果与人体数据的相关性提升至0.85以上。
2、微流控芯片皮肤模型:器官芯片技术将微流控与细胞培养结合,模拟皮肤的动态微环境,包括血流灌注、细胞间通讯等,测试结果更接近人体真实情况。
3、高内涵筛选技术:结合自动化显微镜和图像分析软件,可在单细胞水平同时检测多个生物学指标(如细胞活力、凋亡、自噬、炎症因子等),实现多靶点、多机制的综合评估。
4、AI预测模型:基于大量体外测试数据和人体临床数据训练的人工智能模型,可根据成分结构和体外活性数据预测人体功效,辅助配方设计和功效验证。
5、标准化进程:2025年,《化妆品抗皱功效评价指南》(GB/T 35826-2025)、《化妆品滋养功效测试方法》(T/CAFFCI 2023)等标准相继发布,体外功效测试的方法学标准化不断提升。
体外功效测试并非“靠谱”或“不靠谱”的二元命题,而是取决于测试目的和验证阶段。在配方筛选和机制研究阶段,体外测试是高效、科学、可靠的工具;在最终功效宣称验证阶段,则需要以人体临床测试为准。科学的产品开发应采用“体外初筛→3D皮肤模型验证→人体临床测试”的分阶段策略,充分发挥各类测试方法的优势。随着3D皮肤模型、器官芯片、AI预测等技术的不断发展,体外测试与人体数据的相关性将持续提升,未来体外测试将在化妆品功效验证中扮演更加重要的角色。
汇策集团轻工检测是一家专注于化妆品、日化品领域的第三方检测机构,具备CNAS、CMA双重资质认证。我们提供从体外功效测试(自由基清除、胶原蛋白合成、酪氨酸酶抑制等)到人体临床测试的全流程功效验证服务,帮助企业科学筛选配方、精准验证功效、合规编制功效宣称摘要。欢迎联系专业工程师获取一对一检测方案咨询与报价。
alt="微信二维码">